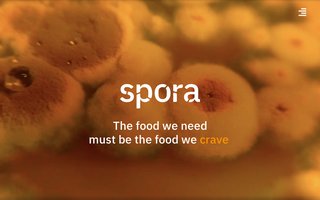

sort:
domain
registrant
city
captured ↓
created
expires
first seen
last seen
|
filter:
screenshots
errors
pending
all
|
export:
[csv]
[json]
|
278770 results · page 45/1394
| domain | registrant | city | code | captured | first seen | last seen | status | |
|---|---|---|---|---|---|---|---|---|

|
focustaepperoggulve.dk | FOCUS TÆPPER OG GULVE ApS | Silkeborg | DK | 2026-04-29 | 2026-01-16 | 2026-04-19 | ok |

|
hipsters.dk | PILANTO ApS | Rødding | DK | 2026-04-29 | 2026-01-16 | 2026-04-17 | ok |

|
fundaygames.dk | Funday Games ApS | Aarhus C | DK | 2026-04-29 | 2026-01-16 | 2026-04-17 | ok |

|
hjaltewehner.dk | Rasmus Wehner | Højbjerg | DK | 2026-04-29 | 2026-01-16 | 2026-04-17 | ok |

|
pbang.dk | pbang++ People Search & Selection | Storvorde | DK | 2026-04-29 | 2026-01-16 | 2026-04-17 | ok |

|
viggojonasen.dk | Katrine Jonasen | Højbjerg | DK | 2026-04-29 | 2026-01-16 | 2026-04-17 | err |

|
opusconsult.dk | OPUS CONSULT ApS | Egå | DK | 2026-04-29 | 2026-01-16 | 2026-04-17 | ok |

|
hostonline.dk | TS COMPUTER ApS | Aarhus V | DK | 2026-04-29 | 2026-01-16 | 2026-04-17 | ok |

|
suavida.dk | Dina Weinkouff Hansen | Køge | DK | 2026-04-29 | 2026-01-16 | 2026-04-17 | ok |

|
theilgaards.dk | Mogens Honore Theilgaard | Brøndby | DK | 2026-04-29 | 2026-01-16 | 2026-04-17 | ok |

|
herskerinde.dk | DLC AF 2006 ApS | København Ø | DK | 2026-04-29 | 2026-01-16 | 2026-04-17 | ok |

|
ibenmondrup.dk | Iben Mondrup | København V | DK | 2026-04-29 | 2026-01-16 | 2026-04-17 | ok |

|
alarmapp.dk | VikingC ApS | Silkeborg | DK | 2026-04-29 | 2026-01-16 | 2026-04-17 | ok |

|
klyvoe.dk | Thomas Klyvø | Valby | DK | 2026-04-29 | 2026-01-16 | 2026-04-17 | ok |

|
lejren.dk | Foreningen Børnelejren på Langeland | Stenløse | DK | 2026-04-29 | 2026-01-16 | 2026-04-17 | ok |

|
bj-kloak.dk | LYNGE HAVESERVICE ApS | Slangerup | DK | 2026-04-29 | 2026-01-16 | 2026-04-17 | ok |

|
nopaconsult.dk | NOPA Consult ApS | Vanløse | DK | 2026-04-29 | 2026-01-16 | 2026-04-17 | ok |

|
murer-tommy.dk | Murermester Tommy Pedersen | Gilleleje | DK | 2026-04-29 | 2026-01-16 | 2026-04-17 | ok |

|
metiscompliance.dk | Metis Compliance | Dianalund | DK | 2026-04-29 | 2026-01-16 | 2026-04-17 | ok |

|
mindsetcph.dk | Maiken Mogensen | Frederikssund | DK | 2026-04-29 | 2026-01-16 | 2026-04-17 | ok |

|
hovmand-vvs.dk | Hovmand VVS Teknik ApS | Vejle | DK | 2026-04-29 | 2026-01-16 | 2026-04-17 | ok |

|
ptinstitute.dk | Kasper Danborg | Kongens Lyngby | DK | 2026-04-29 | 2026-01-16 | 2026-04-17 | ok |

|
webwoman.dk | Lisbeth Scharling Jacobsen | Langå | DK | 2026-04-29 | 2026-01-16 | 2026-04-17 | ok |

|
terndrupif.dk | Terndrup Idrætsforening, Fodboldafd. | Terndrup | DK | 2026-04-29 | 2026-01-16 | 2026-04-17 | ok |

|
toemrerogsnedker.dk | SKALLEBØLLE TØMRER- OG SNEDKERFORRET… | Vissenbjerg | DK | 2026-04-29 | 2026-01-16 | 2026-04-17 | ok |

|
as3.dk | AS3 A/S | Viby J | DK | 2026-04-29 | 2026-01-16 | 2026-04-17 | ok |

|
inzet.dk | inZet | Kokkedal | DK | 2026-04-29 | 2026-01-16 | 2026-04-17 | ok |

|
coopferie.dk | COOP DANMARK A/S | Albertslund | DK | 2026-04-29 | 2026-01-16 | 2026-04-17 | ok |

|
lumbymolle.dk | Foreningen "Lumby Møllegård" | Odense N | DK | 2026-04-29 | 2026-01-16 | 2026-04-19 | ok |

|
fredensborggruppe.dk | Fredensborg Gruppe | Fredensborg | DK | 2026-04-29 | 2026-01-16 | 2026-04-17 | ok |

|
hgatm.dk | Ole Peter Hyldig | Næstved | DK | 2026-04-29 | 2026-01-16 | 2026-04-17 | ok |

|
thorupstrand.dk | VisitNature | Vesløs | DK | 2026-04-29 | 2026-01-16 | 2026-04-17 | ok |

|
tommynguyen.dk | Dansk-IT-Konsulent | Albertslund | DK | 2026-04-29 | 2026-01-16 | 2026-04-17 | ok |

|
nauk.dk | Obsidian Digital A/S | København Ø | DK | 2026-04-29 | 2026-01-16 | 2026-04-17 | ok |

|
exiles.dk | DTU Exiles RUFC | Frederiksberg | DK | 2026-04-29 | 2026-01-16 | 2026-04-19 | ok |

|
dansktoiletudlejning.dk | TOA HOLDING ApS | Viby Sjælland | DK | 2026-04-29 | 2026-01-16 | 2026-04-19 | ok |

|
jerneskakklub.dk | Ib Klitaa | Esbjerg Ø | DK | 2026-04-29 | 2026-01-16 | 2026-04-19 | ok |

|
bysantana.dk | Sanders & co. | Frederiksberg C | DK | 2026-04-29 | 2026-01-16 | 2026-04-19 | ok |

|
pizzo.dk | VIMESO.marketing | Slagelse | DK | 2026-04-29 | 2026-01-16 | 2026-04-17 | err |

|
pplus.dk | P+, Pensionskassen for Akademikere | Frederiksberg | DK | 2026-04-29 | 2026-01-16 | 2026-04-19 | err |

|
webdisplay.dk | WEBDISPLAY | Middelfart | DK | 2026-04-29 | 2026-01-16 | 2026-04-19 | ok |

|
rjmb.dk | Robert Benson | Stenlille | DK | 2026-04-29 | 2026-01-16 | 2026-04-19 | ok |

|
bagtanker.dk | Morten Bjerrum | Roskilde | DK | 2026-04-29 | 2026-01-16 | 2026-04-19 | ok |

|
wass-heilesen.dk | René Wass-Heilesen | Græsted | DK | 2026-04-29 | 2026-01-16 | 2026-04-19 | ok |

|
elrik.dk | Anders Kristian Ørskov | Bryrup | DK | 2026-04-29 | 2026-01-16 | 2026-04-17 | ok |

|
bilbasen.dk | Vend Marketplaces ApS | København K | DK | 2026-04-29 | 2026-01-16 | 2026-04-17 | ok |

|
tandlaegeibindslev.dk | Høj Data ApS | Hirtshals | DK | 2026-04-29 | 2026-01-16 | 2026-04-17 | ok |

|
lene-uhrenholt.dk | Erhvervspsykolog Lene Uhrenholt | Hadsten | DK | 2026-04-29 | 2026-01-16 | 2026-04-17 | ok |

|
velt.dk | VELT ApS | Vanløse | DK | 2026-04-29 | 2026-01-16 | 2026-04-17 | ok |

|
bonnie-tyler.dk | Jan Olesen | Frederikshavn | DK | 2026-04-29 | 2026-01-16 | 2026-04-17 | ok |

|
karstenvogel.dk | Karsten Vogel | Frederiksberg | DK | 2026-04-29 | 2026-01-16 | 2026-04-17 | ok |

|
martinellis.dk | OrderYOYO A/S | København V | DK | 2026-04-29 | 2026-01-16 | 2026-04-17 | ok |

|
prtext.dk | Pia Riedel | København K | DK | 2026-04-29 | 2026-01-16 | 2026-04-17 | ok |

|
bygovenpaa.dk | UCL Erhvervsakademi & Professionshøj… | Odense M | DK | 2026-04-29 | 2026-01-16 | 2026-04-17 | ok |

|
grundejerforeningenbuske.dk | Johnny René Meilstrup Lauridsen | Hvalsø | DK | 2026-04-29 | 2026-01-16 | 2026-04-17 | ok |

|
biesrestaurant.dk | BIE'S BRYGHUS ApS | Hobro | DK | 2026-04-29 | 2026-01-16 | 2026-04-17 | ok |

|
froebutikken.dk | Diane Nielsen | Middelfart | DK | 2026-04-29 | 2026-01-16 | 2026-04-17 | ok |

|
provinsbyer.dk | AScon Business Services 2020 | Løgumkloster | DK | 2026-04-29 | 2026-01-16 | 2026-04-17 | ok |

|
sp-np.dk | Newparts | Nordborg | DK | 2026-04-29 | 2026-01-16 | 2026-04-17 | ok |

|
hotelpetra.dk | Copenhagen Design Hotels ApS | København NV | DK | 2026-04-29 | 2026-01-16 | 2026-04-17 | ok |

|
bygge-magasinet.dk | Creek Media | Svenstrup J | DK | 2026-04-29 | 2026-01-16 | 2026-04-17 | ok |

|
summitweek.dk | ML Travel Group ApS | København K | DK | 2026-04-29 | 2026-01-16 | 2026-04-17 | ok |

|
clothestoperfect.dk | Mads Scheibye Würtz | Valby | DK | 2026-04-29 | 2026-01-16 | 2026-04-17 | ok |

|
skivebyarkiv.dk | STANDOUT A/S | København S | DK | 2026-04-29 | 2026-01-16 | 2026-04-17 | ok |

|
ostedefterskole.dk | OSTED FRI OG EFTERSKOLE | Lejre | DK | 2026-04-29 | 2026-01-16 | 2026-04-17 | ok |

|
kkom.dk | Ib Konrad Jensen | Frederiksberg | DK | 2026-04-29 | 2026-01-16 | 2026-04-17 | ok |

|
lindeberg-tech.dk | LINDEBERG TECH ApS | Karlslunde | DK | 2026-04-29 | 2026-01-16 | 2026-04-17 | ok |

|
jsc.dk | Jan Skov Christensen | Ryslinge | DK | 2026-04-29 | 2026-01-16 | 2026-04-17 | ok |

|
saxilcykler.dk | TNT Cykler ApS | København Ø | DK | 2026-04-29 | 2026-01-16 | 2026-04-19 | ok |

|
boernlille.dk | Annie Kristensen | Grindsted | DK | 2026-04-29 | 2026-01-16 | 2026-04-19 | ok |

|
gl.dk | Gråsten Landbrugsskole | Gråsten | DK | 2026-04-29 | 2026-01-16 | 2026-04-19 | ok |

|
dinfertilitet.dk | Camilla Ulsø Andersen | Holstebro | DK | 2026-04-29 | 2026-01-16 | 2026-04-19 | ok |

|
sapi.dk | Pajor ApS | Nykøbing F | DK | 2026-04-29 | 2026-01-16 | 2026-04-17 | ok |

|
coasteeringbornholm.dk | Tejn Idrætsforening | Allinge | DK | 2026-04-29 | 2026-01-16 | 2026-04-19 | ok |

|
hobrogarden.dk | Hobro Garden | Hobro | DK | 2026-04-29 | 2026-01-16 | 2026-04-19 | ok |

|
detgyldneoverblik.dk | Simon Svendsen | Odense SV | DK | 2026-04-29 | 2026-01-16 | 2026-04-19 | ok |

|
surf-vosnaes.dk | Simon Sloth Mahler-Andersen | Skødstrup | DK | 2026-04-29 | 2026-01-16 | 2026-04-19 | ok |

|
lyse-consulting.dk | Jens Ove Lysemose | Værløse | DK | 2026-04-29 | 2026-01-16 | 2026-04-19 | ok |

|
duemoseparkii.dk | E/F Duemosepark II | Farum | DK | 2026-04-29 | 2026-01-16 | 2026-04-19 | ok |

|
restaurantlilleheden.dk | Restaurant Lilleheden | Hirtshals | DK | 2026-04-29 | 2026-01-16 | 2026-04-17 | ok |

|
koaladesigns.dk | KOALA DESIGNS ApS | Næstved | DK | 2026-04-29 | 2026-01-16 | 2026-04-19 | ok |

|
haandvaegt.dk | Escalate ApS | Frederiksberg | DK | 2026-04-29 | 2026-01-16 | 2026-04-19 | ok |

|
skiltegaarden.dk | SKILTEGÅRDEN HERNING A/S | Herning | DK | 2026-04-29 | 2026-01-16 | 2026-04-17 | ok |

|
fjellerad.dk | Arne Fjellerad | Taastrup | DK | 2026-04-29 | 2026-01-16 | 2026-04-17 | ok |

|
foreningenlanternen.dk | Foreningen Lanternen | Herlev | DK | 2026-04-29 | 2026-01-16 | 2026-04-17 | ok |

|
mariannevaev.dk | TUE KERAMIK ApS | Fårevejle | DK | 2026-04-29 | 2026-01-16 | 2026-04-17 | ok |

|
agerstien.dk | Niels Steffen Nielsen | Gelsted | DK | 2026-04-29 | 2026-01-16 | 2026-04-17 | ok |

|
savery.dk | Martin Rune Savery | Måløv | DK | 2026-04-29 | 2026-01-16 | 2026-04-17 | ok |

|
lyttehaven.dk | ONCOTYPE ApS | København Ø | DK | 2026-04-29 | 2026-01-16 | 2026-04-17 | ok |

|
jcn-bolig.dk | JCN Bolig A/S | Vildbjerg | DK | 2026-04-29 | 2026-01-16 | 2026-04-17 | ok |

|
mariasterapirum.dk | Marias terapirum | Hvidovre | DK | 2026-04-29 | 2026-01-16 | 2026-04-17 | ok |

|
hmhsmykker.dk | Holger Møller Hansen | Valby | DK | 2026-04-29 | 2026-01-16 | 2026-04-17 | ok |

|
dansk-regnskab.dk | Henrik San Miguel Mogensen | Aarhus C | DK | 2026-04-29 | 2026-01-16 | 2026-04-17 | ok |

|
favrskovhavepleje.dk | Favrskov Havepleje ApS | Hadsten | DK | 2026-04-29 | 2026-01-16 | 2026-04-17 | ok |

|
jt-byg.dk | Auxo ApS | Esbjerg Ø | DK | 2026-04-29 | 2026-01-16 | 2026-04-17 | ok |

|
eltronic.dk | ELTRONIC A/S | Hedensted | DK | 2026-04-29 | 2026-01-16 | 2026-04-17 | ok |

|
liserovsing.dk | CRE ApS | Charlottenlund | DK | 2026-04-29 | 2026-01-16 | 2026-04-17 | ok |

|
overvindingeforsamlingshus.dk | OVERVINDINGE FORSAMLINGSHUS | Vordingborg | DK | 2026-04-29 | 2026-01-16 | 2026-04-17 | ok |

|
peterhovmand.dk | Peter Andreas Hovmand | Græsted | DK | 2026-04-29 | 2026-01-16 | 2026-04-17 | ok |

|
lindamassage.dk | Linda Massage Vejen | Vejen | DK | 2026-04-29 | 2026-01-16 | 2026-04-17 | ok |

|
henriksprodukt.dk | PRODUKTHANDEL | Tim | DK | 2026-04-29 | 2026-01-16 | 2026-04-17 | ok |

|
epicent.dk | EPICENT PUBLIC RELATIONS A/S | Egå | DK | 2026-04-29 | 2026-01-16 | 2026-04-17 | ok |

|
jensrasmussen-musik.dk | Jens Rasmussen | Sabro | DK | 2026-04-29 | 2026-01-16 | 2026-04-17 | ok |

|
svenrus.dk | Sven Erik Marinus Christensen | Birkerød | DK | 2026-04-29 | 2026-01-16 | 2026-04-17 | ok |

|
lc-k.dk | Lægecenter Korsør | Korsør | DK | 2026-04-29 | 2026-01-16 | 2026-04-17 | ok |

|
sand-til-fliser.dk | PILANTO ApS | Rødding | DK | 2026-04-29 | 2026-01-16 | 2026-04-17 | ok |

|
taxhelper.dk | Tax Helper ApS | København Ø | DK | 2026-04-29 | 2026-01-16 | 2026-04-17 | ok |

|
agrovi.dk | Agrovi I/S | Hillerød | DK | 2026-04-29 | 2026-01-16 | 2026-04-17 | ok |

|
maxint.dk | Shahrzad Mohammadpour | Ishøj | DK | 2026-04-29 | 2026-01-16 | 2026-04-17 | ok |

|
xn--varmepumpe-frederiksvrk-t9b.dk | PILANTO ApS | Rødding | DK | 2026-04-29 | 2026-01-16 | 2026-04-17 | ok |

|
camillakamstrup.dk | Camilla Maria Kamstrup Knak | Hvidovre | DK | 2026-04-29 | 2026-01-16 | 2026-04-17 | ok |

|
byguldager.dk | Vibeke Silke Camille Guldager | Rødovre | DK | 2026-04-29 | 2026-01-16 | 2026-04-17 | ok |

|
mangal.dk | Mike Fogelberg Mangal | Odense C | DK | 2026-04-29 | 2026-01-16 | 2026-04-17 | ok |

|
sortsjov.dk | Nicolai Sørensen | Skælskør | DK | 2026-04-29 | 2026-01-16 | 2026-04-17 | ok |

|
bodiljohannej.dk | BJ Rådgivning | Horsens | DK | 2026-04-29 | 2026-01-16 | 2026-04-17 | ok |

|
xn--ideer-til-hndarbejde-6zb.dk | Jonas Holm | Roskilde | DK | 2026-04-29 | 2026-01-16 | 2026-04-19 | ok |

|
mollersgrill.dk | Anders Møller | Vordingborg | DK | 2026-04-29 | 2026-01-16 | 2026-04-17 | err |

|
re-cast.dk | STANDOUT A/S | København S | DK | 2026-04-29 | 2026-01-16 | 2026-04-17 | ok |

|
xn--ldreomsorg-c6a.dk | Benny Tarillon Hansen | Kolding | DK | 2026-04-29 | 2026-01-16 | 2026-04-19 | ok |

|
kosmetolog-missmaja.dk | Maja Fredsbo Pedersen | Hadsten | DK | 2026-04-29 | 2026-01-16 | 2026-04-19 | ok |

|
bluetrain.dk | BLUE TRAIN | Kokkedal | DK | 2026-04-29 | 2026-01-16 | 2026-04-19 | ok |

|
venlighund.dk | Joan Susanne Andersen | Faxe | DK | 2026-04-29 | 2026-01-16 | 2026-04-19 | ok |

|
sallingradio.dk | SALLING RADIO | Roslev | DK | 2026-04-29 | 2026-01-16 | 2026-04-19 | ok |

|
tophoj.dk | Ole Tophøj | Herlev | DK | 2026-04-29 | 2026-01-16 | 2026-04-19 | ok |

|
molsbjergehereford.dk | FORPAGTER NIELS ANDERSEN | Ebeltoft | DK | 2026-04-29 | 2026-01-16 | 2026-04-19 | ok |

|
brabantia-online.dk | Nicebuy.dk | Hadsten | DK | 2026-04-29 | 2026-01-16 | 2026-04-17 | ok |
|
spora.dk | Spora ApS | København K | DK | 2026-04-29 | 2026-01-16 | 2026-04-17 | ok |

|
freifeldtpr.dk | Yael Freifeldt | København Ø | DK | 2026-04-29 | 2026-01-16 | 2026-04-19 | ok |

|
optibiz.dk | Kristian Rud Michaelsen | Hedensted | DK | 2026-04-29 | 2026-01-16 | 2026-04-17 | ok |

|
barndomskriger.dk | Mille Dalsgård | Hårlev | DK | 2026-04-29 | 2026-01-16 | 2026-04-17 | ok |

|
musikforni.dk | Musik før Ni | Hvalsø | DK | 2026-04-29 | 2026-01-16 | 2026-04-17 | ok |

|
leoniadvokater.dk | LEONI ADVOKATER ADVOKATPARTNERSELSKA… | Viborg | DK | 2026-04-29 | 2026-01-16 | 2026-04-17 | ok |

|
faskinen.dk | Asimic ApS | Gram | DK | 2026-04-29 | 2026-01-16 | 2026-04-17 | ok |

|
designcircus.dk | Birgit Tarp | Gentofte | DK | 2026-04-29 | 2026-01-16 | 2026-04-17 | ok |

|
madsals.dk | Mads Als Andersen | Aarhus C | DK | 2026-04-29 | 2026-01-16 | 2026-04-17 | ok |

|
klanherman.dk | Anders Birger Andersen | Hinnerup | DK | 2026-04-29 | 2026-01-16 | 2026-04-17 | ok |

|
tufferne.dk | Peter Tony Tufvesson | Korsør | DK | 2026-04-29 | 2026-01-16 | 2026-04-17 | ok |

|
updatebot.dk | Visualize-it | Tilst | DK | 2026-04-29 | 2026-01-16 | 2026-04-17 | err |

|
nempizza.dk | RESTO / eRestaurant | Åbyhøj | DK | 2026-04-29 | 2026-01-16 | 2026-04-17 | ok |

|
3bmholding.dk | Michael Brogaard Munkemose | København N | DK | 2026-04-29 | 2026-01-16 | 2026-04-17 | ok |

|
lydeking-olesen.dk | Mette Lydeking Olesen | København K | DK | 2026-04-29 | 2026-01-16 | 2026-04-17 | ok |

|
hellehejmdal.dk | Klinik for Fodterapi Helle Hejmdal | Solrød Strand | DK | 2026-04-29 | 2026-01-16 | 2026-04-17 | ok |

|
findformen.dk | MERESALG ApS | Kolding | DK | 2026-04-29 | 2026-01-16 | 2026-04-17 | ok |

|
callme.dk | Norlys Mobil A/S | København S | DK | 2026-04-29 | 2026-01-16 | 2026-04-19 | ok |

|
psykologdalby.dk | Gitte Dalby | Juelsminde | DK | 2026-04-29 | 2026-01-16 | 2026-04-19 | ok |

|
taagemosedyreklinik.dk | Pouline Vestergaard Grosbøl | Karise | DK | 2026-04-29 | 2026-01-16 | 2026-04-17 | ok |

|
audiosupport.dk | Morten Dybdal Larsen | Nørresundby | DK | 2026-04-29 | 2026-01-16 | 2026-04-17 | ok |

|
beerticker.dk | Danske Ølentusiaster | Ballerup | DK | 2026-04-29 | 2026-01-16 | 2026-04-17 | ok |

|
clausandersen-terapi.dk | Claus Nicolaj Andersen | Kolding | DK | 2026-04-29 | 2026-01-16 | 2026-04-19 | ok |

|
studinen.dk | Rapid ApS | Lystrup | DK | 2026-04-29 | 2026-01-16 | 2026-04-17 | err |

|
shkirke.dk | Michael Søndberg-Madsen | Gjern | DK | 2026-04-29 | 2026-01-16 | 2026-04-17 | ok |

|
heidijacobsen.dk | Bo Jacobsen | Randers SØ | DK | 2026-04-29 | 2026-01-16 | 2026-04-19 | ok |

|
sdrdonbaek.dk | Lars Levin-Jensen | Roskilde | DK | 2026-04-29 | 2026-01-16 | 2026-04-17 | ok |

|
lyngpetersvej.dk | Peter Prisholm Sørensen | Risskov | DK | 2026-04-29 | 2026-01-16 | 2026-04-19 | ok |

|
carcommerce.dk | Stacc Bytelab A/S | Aarhus C | DK | 2026-04-29 | 2026-01-16 | 2026-04-17 | ok |

|
rytkjaerskov.dk | Mathias Rytkjær Skov Rich | Middelfart | DK | 2026-04-29 | 2026-01-16 | 2026-04-19 | ok |

|
speciallaege-wanscher.dk | Speciallæge Jens Højberg Wanscher | Kolding | DK | 2026-04-29 | 2026-01-16 | 2026-04-19 | ok |

|
kaiseki2970.dk | Nord Intelligent Center ApS | Kongens Lyngby | DK | 2026-04-29 | 2026-01-16 | 2026-04-19 | ok |

|
sabroifgymnastik.dk | Sabro IF Gymnastik | Sabro | DK | 2026-04-29 | 2026-01-16 | 2026-04-19 | ok |

|
gamborgen.dk | Gamborg Kultur- og Friluftshus | Middelfart | DK | 2026-04-29 | 2026-01-16 | 2026-04-19 | ok |

|
xn--studenterkrsel-stjylland-9pcf.dk | Konge studenterkørsel | Hadsten | DK | 2026-04-29 | 2026-01-16 | 2026-04-19 | ok |

|
siak.dk | Socialdemokratiet i Aarhus kommune | Aarhus C | DK | 2026-04-29 | 2026-01-16 | 2026-04-19 | ok |

|
lemforsamlingshus.dk | Verner Kongsted | Randers NØ | DK | 2026-04-29 | 2026-01-16 | 2026-04-19 | ok |

|
sejs-bakker-camping.dk | Klaus Dam | Silkeborg | DK | 2026-04-29 | 2026-01-16 | 2026-04-19 | ok |

|
onebowl.dk | Jebahar Allwin Jeyaraj Vincent | Ballerup | DK | 2026-04-29 | 2026-01-16 | 2026-04-19 | ok |

|
koege-bed-breakfast.dk | Hans Munk Jensen | Køge | DK | 2026-04-29 | 2026-01-16 | 2026-04-19 | ok |

|
saltskrub.dk | Danica Skincare ApS | Frederiksværk | DK | 2026-04-29 | 2026-01-16 | 2026-04-17 | ok |

|
egorip.dk | René Petersen | København S | DK | 2026-04-29 | 2026-01-16 | 2026-04-19 | ok |

|
fuglekvarteret.dk | NPV A/S | Charlottenlund | DK | 2026-04-29 | 2026-01-16 | 2026-04-17 | ok |

|
xn--mrbekmpelse-x8ar.dk | Naturtro ApS | København Ø | DK | 2026-04-29 | 2026-01-16 | 2026-04-19 | ok |

|
vopla.dk | Morten Grodt Hansen | Odense V | DK | 2026-04-29 | 2026-01-16 | 2026-04-17 | ok |

|
bruhn-pedersen.dk | Thomas Bruhn-Pedersen | Dragør | DK | 2026-04-29 | 2026-01-16 | 2026-04-19 | ok |

|
headtrainer.dk | Digicraft ApS | Holbæk | DK | 2026-04-29 | 2026-01-16 | 2026-04-19 | ok |

|
pizzeriadamarino.dk | DA'MARINO vAdmar Fernandes Rodrigues | Nørresundby | DK | 2026-04-29 | 2026-01-16 | 2026-04-17 | ok |

|
nordiccolor.dk | Nordic Color Danmark ApS | Sønderborg | DK | 2026-04-29 | 2026-01-16 | 2026-04-17 | ok |

|
mathildenancy.dk | MN Fitness | København N | DK | 2026-04-29 | 2026-01-16 | 2026-04-17 | ok |

|
livawheel.dk | LivaWheel ApS | Sorø | DK | 2026-04-29 | 2026-01-16 | 2026-04-17 | ok |

|
dlcs.dk | DLCS ApS | Egå | DK | 2026-04-29 | 2026-01-16 | 2026-04-17 | ok |

|
thetradecouncil.dk | Udenrigsministeriet | København K | DK | 2026-04-29 | 2026-01-16 | 2026-04-17 | ok |

|
kreativoplysningskreds.dk | Kreativ Oplysnings Kreds | Næstved | DK | 2026-04-29 | 2026-01-16 | 2026-04-17 | ok |

|
11thhour.dk | 11th Hour Consulting | Hvidovre | DK | 2026-04-29 | 2026-01-16 | 2026-04-17 | ok |

|
ulla-keramik.dk | ULLA KERAMIK | Bagenkop | DK | 2026-04-29 | 2026-01-16 | 2026-04-17 | ok |

|
steinerbutikken.dk | MenuTryk | Fredericia | DK | 2026-04-29 | 2026-01-16 | 2026-04-17 | ok |

|
bestads.dk | Jonas Holm | Roskilde | DK | 2026-04-29 | 2026-01-16 | 2026-04-17 | ok |

|
koldingkirkecenter.dk | Pinsekirken | Kolding | DK | 2026-04-29 | 2026-01-16 | 2026-04-17 | ok |

|
mainico.dk | Maj-Brith Yvonne Nielsen | Børkop | DK | 2026-04-29 | 2026-01-16 | 2026-04-17 | ok |

|
balsam-aalborg.dk | Balsam | Aalborg | DK | 2026-04-29 | 2026-01-16 | 2026-04-17 | ok |

|
hoffmannbyg.dk | Ingolf Hoffmann | Videbæk | DK | 2026-04-29 | 2026-01-16 | 2026-04-17 | ok |

|
ronnesvommehal.dk | RØNNE SVØMMEHAL | Rønne | DK | 2026-04-29 | 2026-01-16 | 2026-04-17 | ok |

|
nbainfo.dk | Kurt Fischer Ravn | Espergærde | DK | 2026-04-29 | 2026-01-16 | 2026-04-17 | ok |

|
kelner.dk | Kelner ApS | København V | DK | 2026-04-29 | 2026-01-16 | 2026-04-17 | ok |

|
ulrikawester.dk | Personlig Træner | Bjæverskov | DK | 2026-04-29 | 2026-01-16 | 2026-04-17 | ok |

|
eacclub.dk | ØK Klubben | København Ø | DK | 2026-04-29 | 2026-01-16 | 2026-04-17 | ok |

|
a-fotograf.dk | A-fotograf | Sorø | DK | 2026-04-29 | 2026-01-16 | 2026-04-17 | ok |

|
adhdcenter.dk | Center for ADHD+ S/I | Aarhus C | DK | 2026-04-29 | 2026-01-16 | 2026-04-17 | ok |

|
xn--lederhjskolen-gnb.dk | The ninesquares ApS | Greve | DK | 2026-04-29 | 2026-01-16 | 2026-04-17 | ok |

|
ku1.dk | MGH-KULTUNAUT ApS | Søborg | DK | 2026-04-29 | 2026-01-16 | 2026-04-17 | ok |

|
rn.dk | Region Nordjylland | Aalborg Øst | DK | 2026-04-29 | 2026-01-16 | 2026-04-17 | ok |

|
marangu.dk | xwave P/S | Jægerspris | DK | 2026-04-29 | 2026-01-16 | 2026-04-17 | ok |

|
maltenet.dk | Lars Maltesen | Græsted | DK | 2026-04-29 | 2026-01-16 | 2026-04-17 | ok |